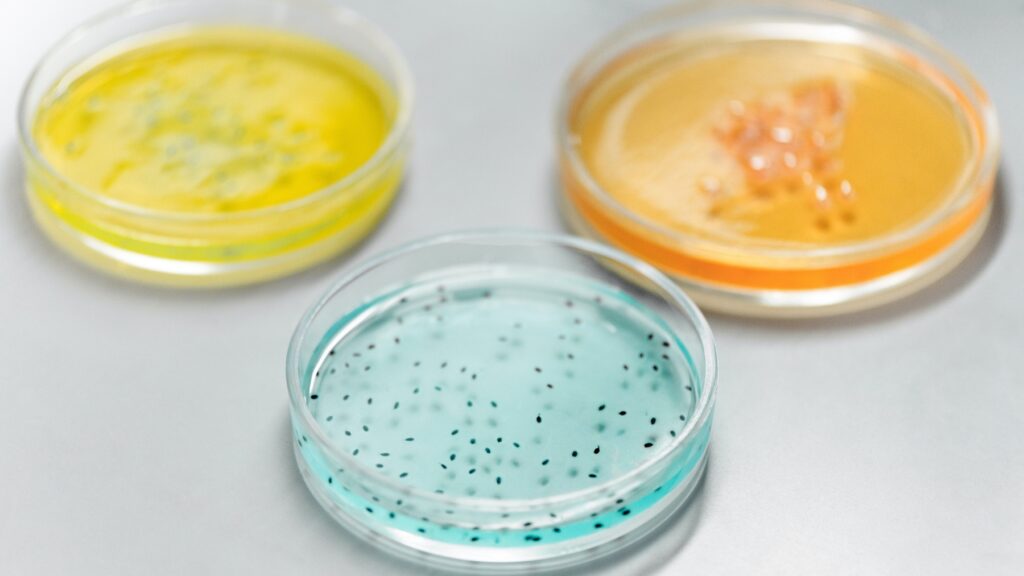

Las bacterias y los virus son algo común en la naturaleza. Aunque ambos comparten algunas características similares, lo cierto es que tienen notables diferencias entre ellas. Una de las cuestiones que en la que más se parecen ambos organismos es en su capacidad para provocar enfermedades para la especie humano o animal.
¿Qué diferencia las bacterias de los virus?
Si hablamos de los virus, hay que entender que la propia naturaleza de la palabra ya significa ‘veneno’ o toxina. Proviene de un origen latino y se trata de una entidad biológica que es capaz de autorreplicarse al entrar en contacto con la máquina celular.
Para poder replicar su contenido y así infectar mucho más, el virus necesita la maquinaria metabólica de la propia célula que invade para replicar su material genético y producir copias del virus original. El proceso es bastante dañino ya que puede perjudicar a la célula de nuestro cuerpo hasta destruirla.
Se trata, por tanto de un parásito intracelular de pequeño tamaño que utiliza ácido nucleico y proteína para causar enfermedades. El último ejemplo que tenemos reciente es el del propio coronavirus.
Por su parte, las bacterias son organismos unicelulares, sin núcleo que les permitan presentarse desnudas, aisladas o en grupo. Son capaces de vivir en cualquier hábitat, incluso en el espacio, convirtiéndolas en un organismo muy abundante en todo el planeta.
Existen de varios tipos: alargada, esféricas o en espiral, y se asocian en grupos que suelen llamarse diplococos. En un estado original, las bacterias, a diferencia de los virus, son beneficiosas para la naturaleza y el propio cuerpo humano, pero muchas pueden cambiar y ser muy perjudiciales para la salud.
Por ejemplo, las bacterias son causantes de enfermedades como la salmonelosis, el cólera o la brucelosis.
Por lo tanto, una de las diferencias notables que tienen bacterias y virus es su tamaño y anatomía. Las bacterias son más grandes, hasta 100 veces más, y cuentan con una pared celular real, así como estructura interna, algo que jamás tendrá un virus.
Estos cuentan con una estructura simple que consiste, por regla general, en un genoma.
Por otro lado, los virus no son capaces de multiplicarse por sí mismos, por lo que necesitan de otras células a las que atacan para ello. Al contrario que los virus, las bacterias si tienen la capacidad de multiplicación gracias a la división celular, al igual que se multiplican las células humanas en nuestro cuerpo.